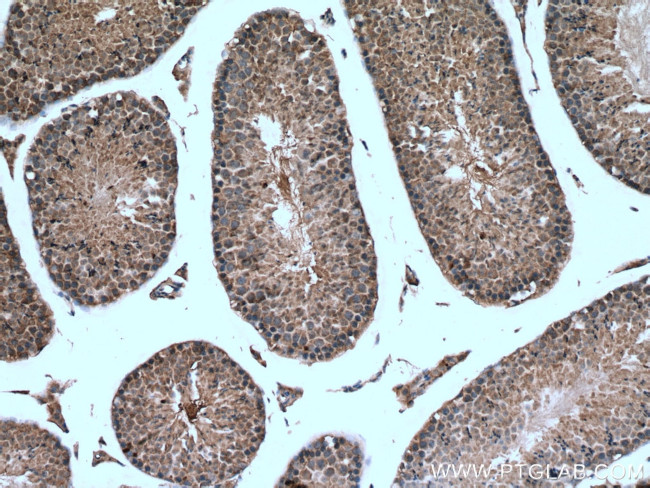
SRPK2 Antibody in Immunohistochemistry (Paraffin) (IHC (P))

Search
Proteintech
SRPK2 Polyclonal Antibody
{{$productOrderCtrl.translations['antibody.pdp.commerceCard.promotion.promotions']}}
{{$productOrderCtrl.translations['antibody.pdp.commerceCard.promotion.viewpromo']}}
{{$productOrderCtrl.translations['antibody.pdp.commerceCard.promotion.promocode']}}: {{promo.promoCode}} {{promo.promoTitle}} {{promo.promoDescription}}. {{$productOrderCtrl.translations['antibody.pdp.commerceCard.promotion.learnmore']}}
产品信息
25417-1-AP
种属反应
宿主/亚型
分类
类型
抗原
偶联物
形式
浓度
规格
纯化类型
保存液
内含物
保存条件
运输条件
产品详细信息
Immunogen sequence: LEREAERKI IEENITSAAP SNDQDGEYCP EVKLKTTGLE EAAEAETAKD NGEAEDQEEK EDAEKENIEK DEDDVDQELA NIDPTWIESP KTNGHIENGP FSLEQQLDDE DDDEEDCPNP EEYNLDEPNA ESDYTYSSSY EQFNGELPNG RHKIPESQFP EFSTSLFSGS LEPVACGSVL SEGSPLTEQE ESSPSHDRSR TVSASSTGDL PKAKTRAADL LV (293-513 aa encoded by BC035214)
靶标信息
SRPK2, along with SRPK1, is most likely the cellular protein kinase mediating HBV core protein phosphorylation during viral infection. It therefore represents an important host cell target for therapeutic intervention in HBV infection. Promotes neuronal apoptosis by up-regulating cyclin-D1 (CCND1) expression. This is done by the phosphorylation of SRSF2, leading to the suppression of p53/TP53 phosphorylation thereby relieving the repressive effect of p53/TP53 on cyclin-D1 (CCND1) expression. Phosphorylates ACIN1, and redistributes it from the nuclear speckles to the nucleoplasm, resulting in cyclin A1 but not cyclin A2 up-regulation. Plays an essential role in spliceosomal B complex formation via the phosphorylation of DDX23/PRP28. Plays a negative role in the regulation of HBV replication through a mechanism not involving the phosphorylation of the core protein but by reducing the packaging efficiency of the pregenomic RNA (pgRNA) without affecting the formation of the viral core particles .
仅用于科研。不用于诊断过程。未经明确授权不得转售。
生物信息学
蛋白别名: H_RG152G17.1a; H_RG152G17.1b; serine kinase SRPK2; Serine/arginine-rich protein-specific kinase 2; serine/arginine-rich splicing factor kinase 2; serine/threonine-protein kinase SRPK2; SFRS protein kinase 2; SR protein kinase 2; SR-protein-specific kinase 2; SRSF protein kinase 2; WUGSC:H_RG152G17.1a
基因别名: SFRSK2; SRPK2
UniProt ID: (Human) P78362
Entrez Gene ID: (Human) 6733